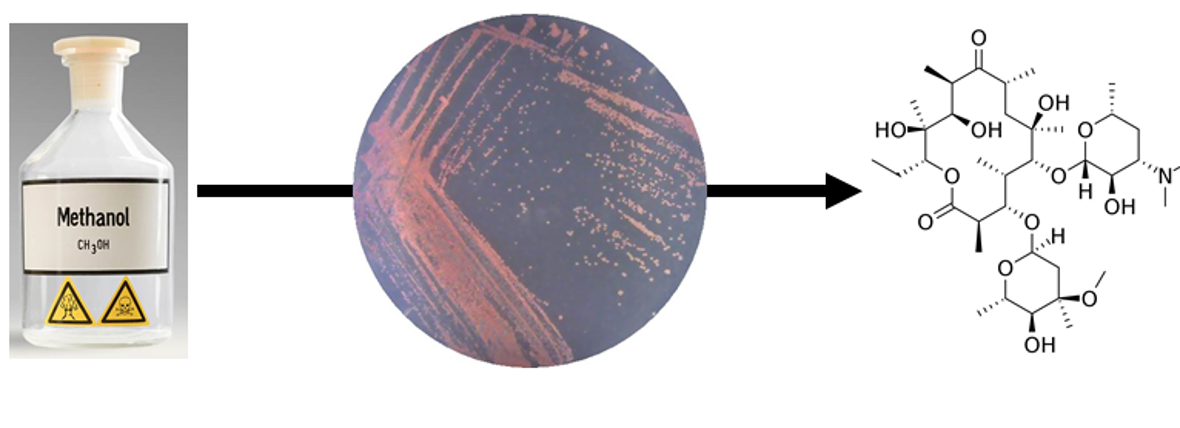

NWO grant gives way to more sustainable production of antibiotics
The opportunity to explore a new, exciting research topic. That is how Lennart Schada von Borzyskowski describes his successful application for the NWO XS grant. It comprises 50,000 euros, which the researcher from the Institute of Biology Leiden (IBL) will spend on investigating a more sustainable approach for producing antibiotics.
‘I will use this grant to explore the production of antibiotics from methanol – a cheap and sustainable raw material – by genetically engineered bacteria,’ Schada von Borzyskowski says. ‘The current production of many antibiotics by so-called Actinobacteria is complex, expensive and unsustainable. We will now try to transfer their antibiotic-producing enzymes to another bacterium, Methylorubrum extorquens, which can utilize methanol for growth. This is highly challenging, but it has the potential to open up a new research field.’
The researcher is eager to start the study. ‘The approach of producing antibiotics from methanol is well-embedded into the research of the IBL on antimicrobial compounds, while adding the facet of sustainable biotechnological production to it. Since this was my first grant application in the Netherlands after arriving in Leiden earlier this year, I am grateful to have received this NWO funding early on. I look forward to exploring similar topics on a larger scale in the future.’
NWO XS grant
This grant is suitable for the initial exploration of highly promising research topics. The proposed research should be ground-breaking and high risk. To qualify for the grant, NWO states that what counts is that all results, be they positive or negative, must contribute to the advancement of science.
